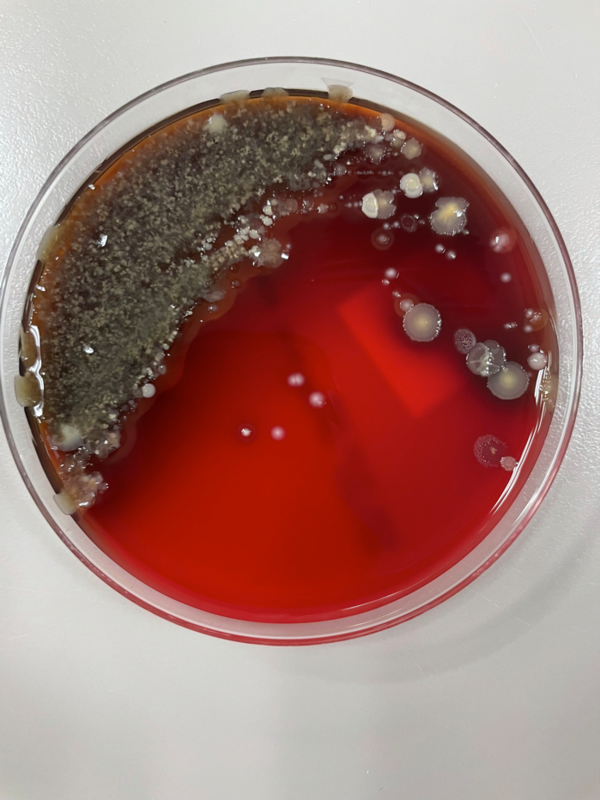
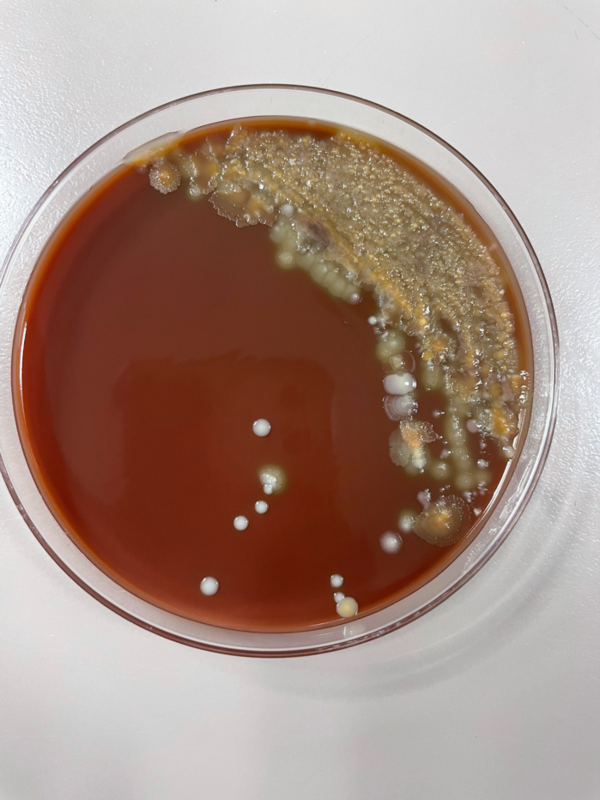
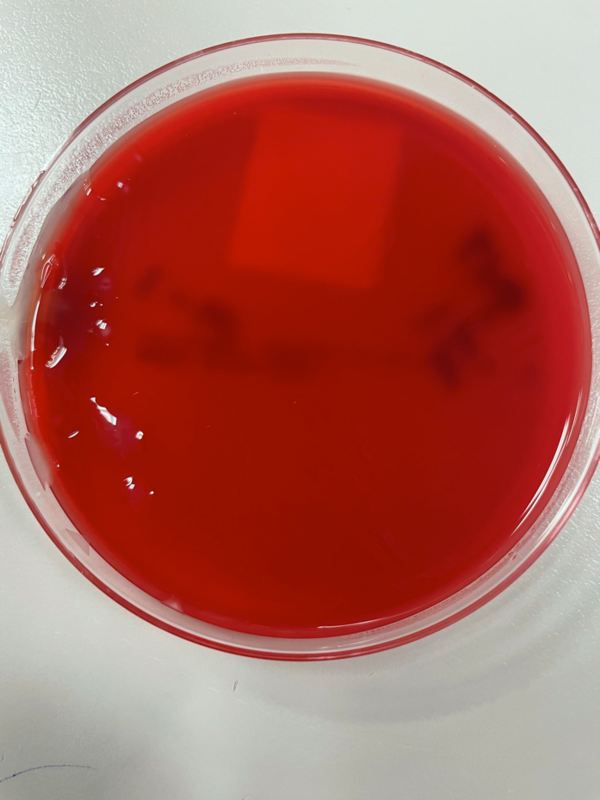
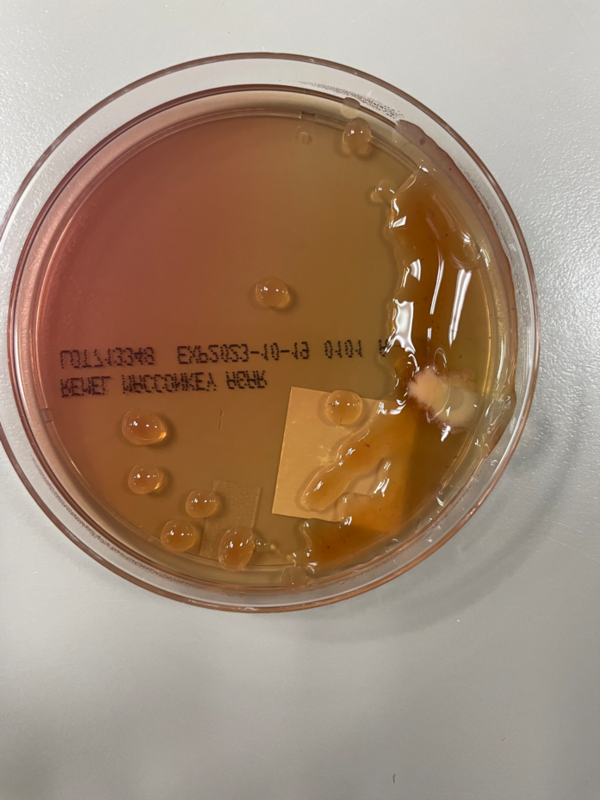

Мужчина 74 лет с диагнозом муковисцидоза (МВ) обратился в клинику для проведения планового анализа мокроты.
На этом приеме у пациента не было легочных жалоб, но при визуализации грудной клетки были выявлены рубцовые изменения и ателектаз правой верхней доли легкого и левой средней доли легкого. На снимках не было признаков легочной инфекции.
Первичный диагноз МВ был поставлен пациенту в возрасте 69 лет после перенесенных рецидивирующих респираторных инфекций, бронхоэктазов и бесплодия. Повышенный уровень хлоридов в поту подтвердил диагноз МВ, а последующее генетическое тестирование показало гетерозиготность по двум мутациям CFTR, вызывающим заболевание: p. Leu206Trp и p. Phe508del. Дополнительный анамнез включает курение и текущие проблемы с поджелудочной железой, вероятно, связанные с МВ. Пациенту назначен элексакафтор/техакафтор/ивакафтор, который, по-видимому, способствует улучшению легочных симптомов, а также дополнительные панкреатические ферменты, которые умеренно улучшают симптоматику со стороны поджелудочной железы. Для контроля лечения и прогрессирования заболевания, а также для выявления возможных скрытых инфекций у пациентов с МВ часто проводится рутинное исследование мокроты. Культура мокроты, взятая у этого же пациента в 2022 г., показала наличие инфекции Pseudomonas fluorescens, что подчеркивает важность рутинного мониторинга заболевания у пациентов с МВ.
Лабораторное обследование
Образец мокроты, взятый у пациента, был подвергнут стандартной обработке и высеян на кровяной, шоколадный, MacConkey, CNA и Burkholderia cepacian агары. Как на кровяном, так и на шоколадном агаре, помимо нормальной флоры ротоглотки, был обнаружен рост микроорганизма с мукоидной морфологией. После выделения мукоидных колоний рост микроорганизмов наблюдался как на чашках кровяного агара, так и на чашках среды МакКонки. Рост на чашках с агаром МакКонки указывал на то, что микроорганизм не является лактозным ферментером, так как колонии были непигментированными, а сам агар оставался розового цвета. По результатам MALDI-ToF мукоидный микроорганизм был идентифицирован как мукоидный штамм Pseudomonas aeruginosa.
Иллюстрация 1. На этой чашке с кровяным агаром наблюдался рост нормальной флоры ротоглотки, но при этом присутствуют бактерии мукоидной морфологии. На чашке присутствует множество цветов, морфологий колоний микроорганизмов.
Иллюстрация 2. Чашка шоколадного агара, на которой наблюдается смешанный рост микроорганизмов. Некоторые колонии желтого цвета с плохо очерченными границами, другие - белого цвета с четко очерченными границами. Было установлено, что большинство колоний, присутствующих на этой чашке, являются нормальной флорой ротоглотки.
Иллюстрация 3. Чашка кровяного агара с мукоидным морфологическим ростом, выделенным с чашки, показанной на илл. 1.
Иллюстрация 4. На среде МакКонки растут бактерии с мукоидной морфологией. Сами бактерии остаются непигментированными, коричневатого цвета, в то время как агар остается розовым. Как цвет колоний, так и цвет агара указывают на то, что данный микроорганизм не является ферментером лактозы.
Обсуждение
Муковисцидоз (МВ) - аутосомно-рецессивное заболевание, способное поражать множество систем органов, включая дыхательную, пищеварительную и репродуктивную системы. Основная причина этого заболевания связана с мутациями в гене трансмембранного регулятора проводимости (CFTR), для которого описано более двух тысяч различных мутаций. У здоровых людей этот ген отвечает за выработку белка, обеспечивающего транспорт солей через различные ткани организм, однако мутировавшие версии этого гена производят белки, которые отсутствуют или дисфункциональны и, таким образом, не могут столь же эффективно способствовать транспорту солей и перемещению воды.
Различные мутации гена CFTR могут приводить к многочисленным клиническим проявлениям, но чаще всего эти мутации влияют на вязкость слизи: густая, липкая слизь и хронические респираторные инфекции считаются отличительной чертой этого заболевания. Кроме того, десятилетия исследований описали дополнительные проявления МВ, включая бесплодие, хронический синусит, поражение поджелудочной железы, а также повышенный риск обезвоживания.
Наиболее распространенным диагностическим тестом для больных МВ является тест на хлориды пота, при котором концентрация хлоридов пота выше 60 ммоль/л свидетельствует о диагнозе МВ и является прямым следствием потери функции белков CFTR. С момента первых описаний МВ в 1935 г. были внедрены программы скрининга новорожденных с целью раннего выявления потенциальных случаев заболевания и улучшения прогноза. Часто скрининг новорожденных направлен на выявление иммунореактивного трипсиногена в крови, поскольку уровень этого химического вещества часто повышен у пациентов с МВ.
Кроме того, анализ ДНК также оказался чрезвычайно полезным инструментом в диагностике больных МВ, но эти анализы ограничены выявлением только наиболее распространенных мутаций и могут ошибочно диагностировать некоторые редкие варианты заболевания. Кроме того, поскольку существует широкий спектр генотипов, вызывающих МВ, у некоторых пациентов симптомы заболевания могут проявляться поздно, но при этом они имеют две мутации CFTR, что объясняет увеличение числа диагнозов, поставленных в зрелом возрасте. Это объясняет, почему в данном случае диагноз был поставлен так поздно: при наличии двух отдельных генных мутаций у пациента могли не проявиться классические симптомы МВ в более раннем возрасте.
Pseudomonas aeruginosa - распространенный патоген, встречающийся у больных МВ и вносящий значительный вклад в заболеваемость и смертность пациентов. P. aeruginosa при инфицировании легких способствует ускоренному снижению легочной функции у больных МВ и, как было показано, проявляет значительную резистентность как к врожденной иммунной системе, так и к антибиотикам благодаря экспрессии специфических факторов вирулентности. Поскольку больные МВ подвержены хроническим легочным инфекциям, было показано, что повторное лечение антибиотиками также способствует развитию адаптивных мутаций P. aeruginosa, что делает этот возбудитель особенно опасным для больных МВ. Универсальность этого возбудителя делает его способным вызывать как острые, так и хронические инфекции, а сохранение P. aeruginosa в дыхательных путях больных МВ до взрослого возраста можно объяснить сложной взаимосвязью между патогенными свойствами организма и различными факторами хозяина.
Поскольку P. aeruginosa имеет репутацию бактерии особо резистентной к антибиотикам, ее особенно трудно лечить у больных МВ, которые регулярно проходят лечение по поводу хронических инфекций. Оптимальным вариантом терапии будет проведение анализа антибиотикочувствительности в образце мокроты, чтобы определить, какой из имеющихся антибиотиков может оказать наибольшее действие на бактерии.
